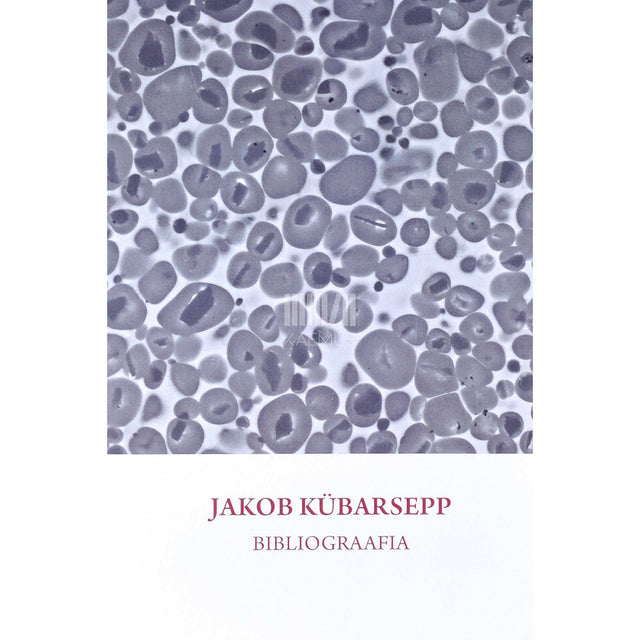
… - Jakob Kübarsepp

Jakob Kübarsepp
Jakob Kübarsepp
Järeletulemise võimalusi ei õnnestunud laadida
- Seisukord: Väga hea (kasutatud)
- Märkused:
- Tallinna Tehnikaülikooli Kirjastus | 2017
- 143 lk | Pehmekaaneline | 165 x 245 mm
- ISBN: 9789949830794
- Keel: eestikeelne
„Jakob Kübarsepp“ on 2017. aastal Tallinna Tehnikaülikooli Kirjastuse väljaandel ilmunud teadus- ja elulooraamat, mis kuulub ülikooli teadlaste ja akadeemiliste töötajate tutvustuste sarja. Teos käsitleb professor Jakob Kübarsepa elu ja teadustegevust, keskendudes eelkõige tema panusele materjalitehnoloogia ja inseneriteaduste arengusse Eestis. Raamat kirjeldab tema teadustööd pulbermetallurgia, kulumiskindluse ja komposiitmaterjalide vallas ning toob esile tema rolli uute uurimissuundade käivitajana ja teaduskoostöö edendajana nii kodu- kui ka välismaal.
Sisuliselt on teos jaotatud kaheks suuremaks osaks. Esimene annab ülevaate Kübarsepa elukäigust, haridusteest ja akadeemilisest karjäärist Tallinna Tehnikaülikoolis, sealhulgas tema tegevusest õppeprorektori ja õppetöö korraldajana. Teine osa keskendub tema teaduslikule loomingule, kirjeldades olulisemaid uurimisprojekte, rahvusvahelisi koostööprogramme ja publikatsioone. Täiendavalt on toodud bibliograafia ja fotomaterjal, mis illustreerib nii teadustööd kui ka isiklikke hetki teadlase elus.
Jakob Kübarsepp (sündinud 1947) on eesti tehnikateadlane, Tallinna Tehnikaülikooli emeriitprofessor ja Eesti Teaduste Akadeemia liige. Ta on avaldanud sadu teadusartikleid, juhendanud hulgaliselt doktoritöid ning pälvinud mitmeid teaduspreemiaid ja teenetemärke. Kübarsepp on rahvusvaheliselt tunnustatud materjalitehnoloogia ekspert, kelle töö tulemused on leidnud rakendust nii tööstuses kui ka teaduses. Käesolev raamat on ühtaegu tunnustus tema senisele tegevusele ja väärtuslik allikas inseneriteaduste ajaloost Eestis.